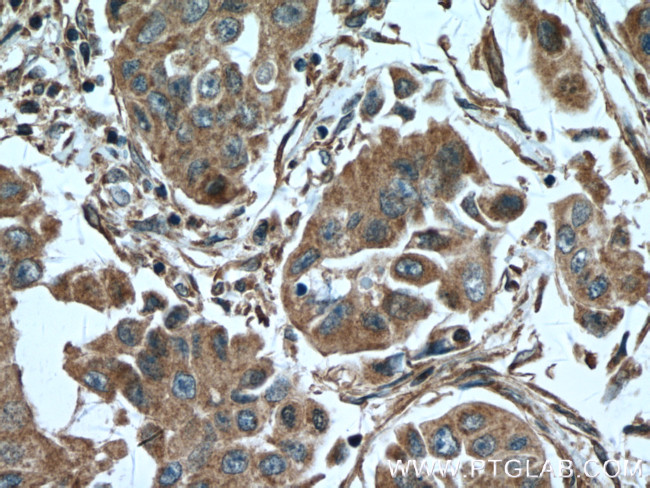
HHIP Antibody in Immunohistochemistry (Paraffin) (IHC (P))

Search
Proteintech
HHIP Polyclonal Antibody
{{$productOrderCtrl.translations['antibody.pdp.commerceCard.promotion.promotions']}}
{{$productOrderCtrl.translations['antibody.pdp.commerceCard.promotion.viewpromo']}}
{{$productOrderCtrl.translations['antibody.pdp.commerceCard.promotion.promocode']}}: {{promo.promoCode}} {{promo.promoTitle}} {{promo.promoDescription}}. {{$productOrderCtrl.translations['antibody.pdp.commerceCard.promotion.learnmore']}}
产品信息
11654-1-AP
宿主/亚型
分类
类型
抗原
偶联物
形式
浓度
规格
保存条件
运输条件
产品详细信息
Immunogen sequence: KHLGGQLLF GPDGFLYIIL GDGMITLDDM EEMDGLSDFT GSVLRLDVDT DMCNVPYSIP RSNPHFNSTN QPPEVFAHGL HDPGRCAVDR HPTDININLT ILCSDSNGKN RSSARILQII KGKDYESEPS LLEFKPFSNG PLVGGFVYRG CQSERLYGSY VFGDRNGNFL TLQQSPVTKQ WQEKPLCLGT SGSCRGYFSG HILGFGEDEL GEVYILSSSK SMTQTHNGKL YKIVDPKRPL MPEECRATVQ PAQTLTSECS RLCRNGYCTP TGKCCCSPGW EGDFCRTAKC EPACRHGGVC VRPNKCLCKK GYLGPQCEQV DRNIRRVTRA GILDQIIDMT SYLLDLTSYI V (351-700 aa encoded by BC025311)
靶标信息
This gene encodes a protein similar to the mouse hedgehog-interacting protein, a regulatory component of the hedgehog signaling pathway. Members of the hedgehog family are evolutionarily conserved proteins which are involved in many fundamental processes in embryonic development, including anteroposterior patterns of limbs and regulation of left-right asymmetry.
仅用于科研。不用于诊断过程。未经明确授权不得转售。